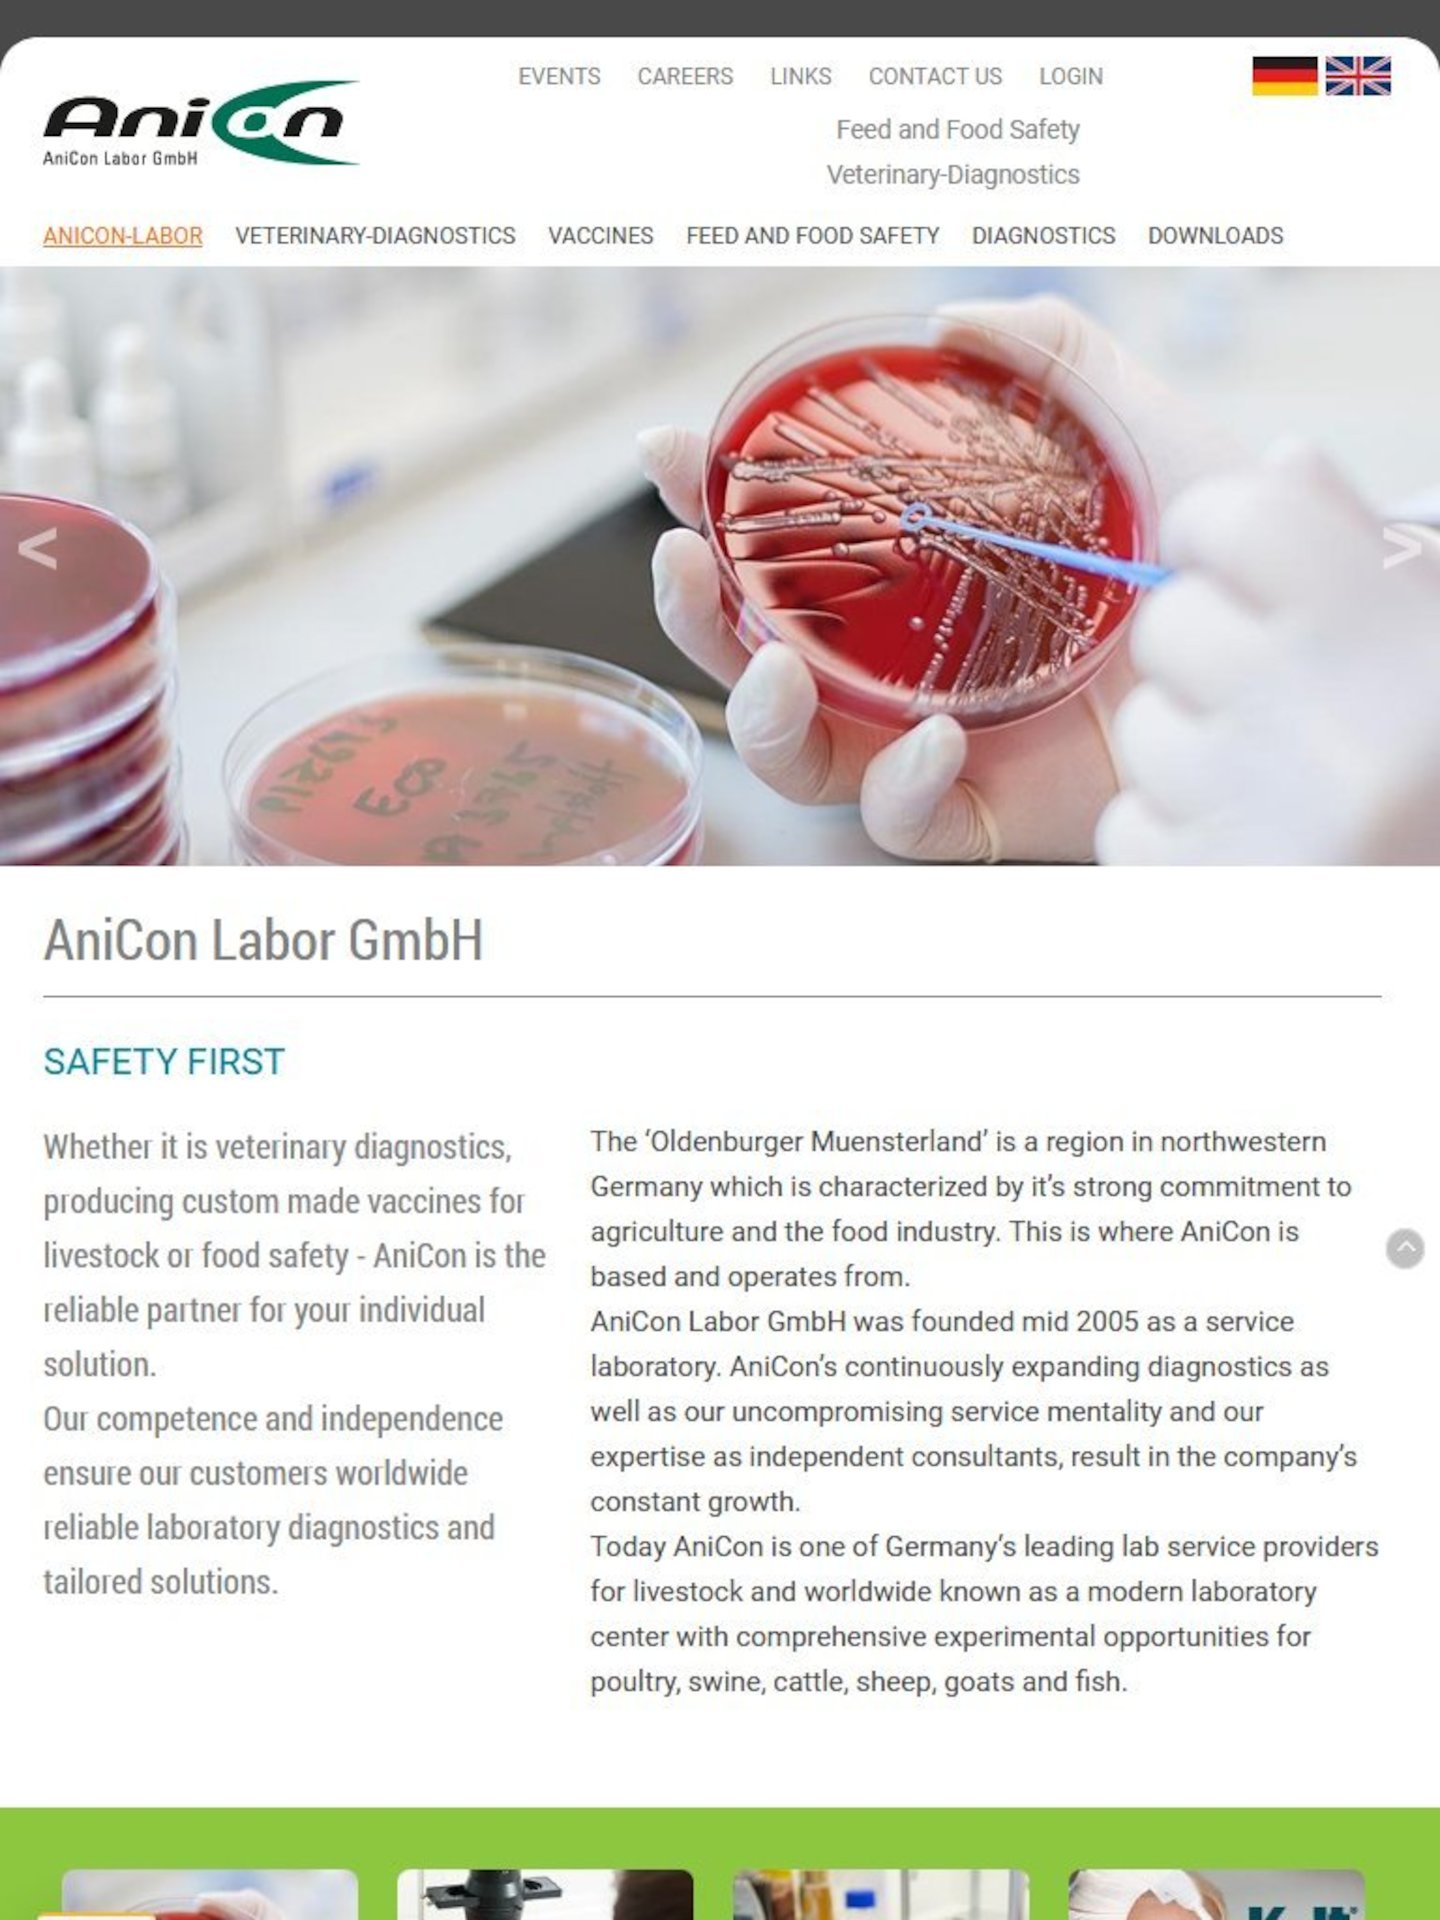
Tablet Screenshot der Website von: AniCon Labor

Die AniCon Labor GmbH aus Höltinghausen ist ein Dienstleister für kundenorientierte Lösungen in den Bereichen der Veterinärdiagnostik, Produktion bestandspezifischer Impfstoffe und Lebensmittelsicherheit.
Die neue, zweisprachige Website www.anicon.eu wurde in Kooperation vom grafikBÜRO Elke Woltering und experia entwickelt. Sie macht auch auf mobilen Endgeräten eine gute Figur, ist übersichtlich und grafisch sehr ansprechend.
Kunden des weltweit bekannten, modernen Laborzentrums können sich hier umfassend über Untersuchungsmöglichkeiten für die Tierarten Rind, Schwein, Geflügel und Fisch informieren und wichtige Formulare hier downloaden.
Für die Zukunft ist die Einbindung einer Labor-Datenbank angedacht - eine weitere sinnvolle Dienstleistung der AniCon Labor GmbH.